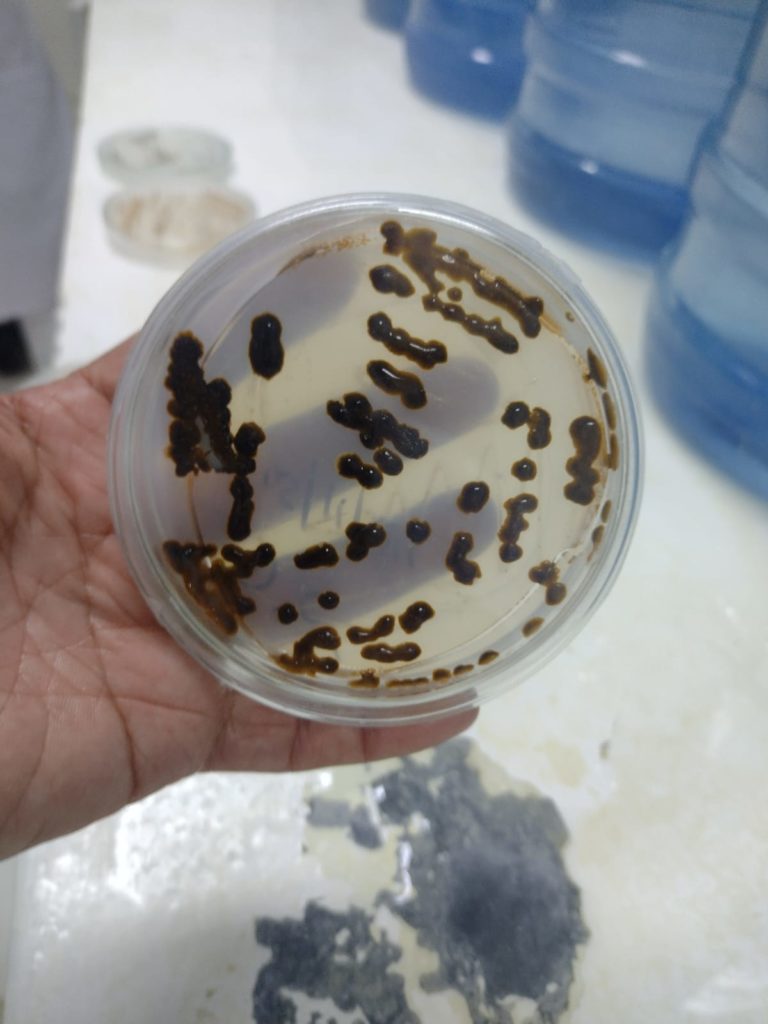

Galicia impulsa su Estrategia de Economía Azul en el Blue Atlantic Forum de Baiona
Baiona acogerá del 12 al 14 de noviembre la cuarta edición del Blue Atlantic Forum (BAF), el principal encuentro sobre economía azul del Arco Atlántico. El evento reunirá a expertos, instituciones y empresas europeas para debatir sobre innovación, sostenibilidad y el desarrollo del mar como motor económico. Como gran novedad, se celebrará el I Foro de la Estrategia de Economía Azul de Galicia, impulsado por la Consellería do Mar.
Baiona será, del 12 al 14 de noviembre de 2025, el punto de encuentro de la economía azul atlántica con la celebración de la IV edición del Blue Atlantic Forum (BAF) en el Parador de Baiona. Este evento, que se ha consolidado como referente europeo, reunirá a instituciones, empresas, investigadores y estudiantes comprometidos con el desarrollo sostenible de los recursos marinos y costeros.


Como novedad destacada, la edición de este año acogerá durante su primera jornada el I Foro de la Estrategia de Economía Azul de Galicia, impulsado por la Consellería do Mar de la Xunta de Galicia y CETMAR. Este nuevo espacio busca fortalecer la gobernanza de las actividades vinculadas al mar en la comunidad, impulsando la cooperación entre políticas públicas, investigación científica y sector privado. El foro incluye una conferencia inaugural del experto Ernesto Penas Lado sobre la gobernanza internacional del mar, dos mesas redondas dedicadas a los sectores tradicionales y emergentes de la economía azul —con participación de representantes de la pesca, la acuicultura, la biotecnología y los puertos— y una dinámica participativa organizada por CETMAR para impulsar la creación de la Red Gallega de la Economía Azul.
La sesión inaugural contará con la presencia de la conselleira do Mar, el presidente de la Xunta de Galicia, el alcalde de Baiona y representantes del Puerto de Vigo, y se centrará en los avances y prioridades de la Estrategia de la Economía Azul de Galicia. Galicia, con su tradición marinera y su tejido productivo vinculado al mar, se presenta como territorio de referencia y laboratorio vivo del desarrollo azul.
El Blue Atlantic Forum se ha convertido en una plataforma clave de cooperación interregional dentro del Arco Atlántico, donde se abordan los desafíos y oportunidades de un sector que abarca desde la pesca y la acuicultura hasta la biotecnología marina, las energías renovables, el turismo costero o el transporte marítimo.
El reconocimiento internacional también avala esta cita: la edición anterior fue distinguida por la organización Green Destinations como una de las Top 100 Responsible Tourism Initiatives del mundo, por su contribución al turismo sostenible y a la difusión de los valores del Atlántico como espacio de innovación y respeto ambiental.
El BAF 2025 combina formato presencial y en línea, facilitando la participación de ponentes y asistentes de distintos países y sectores.
Más información e inscripciones: www.blueatlanticforum.org